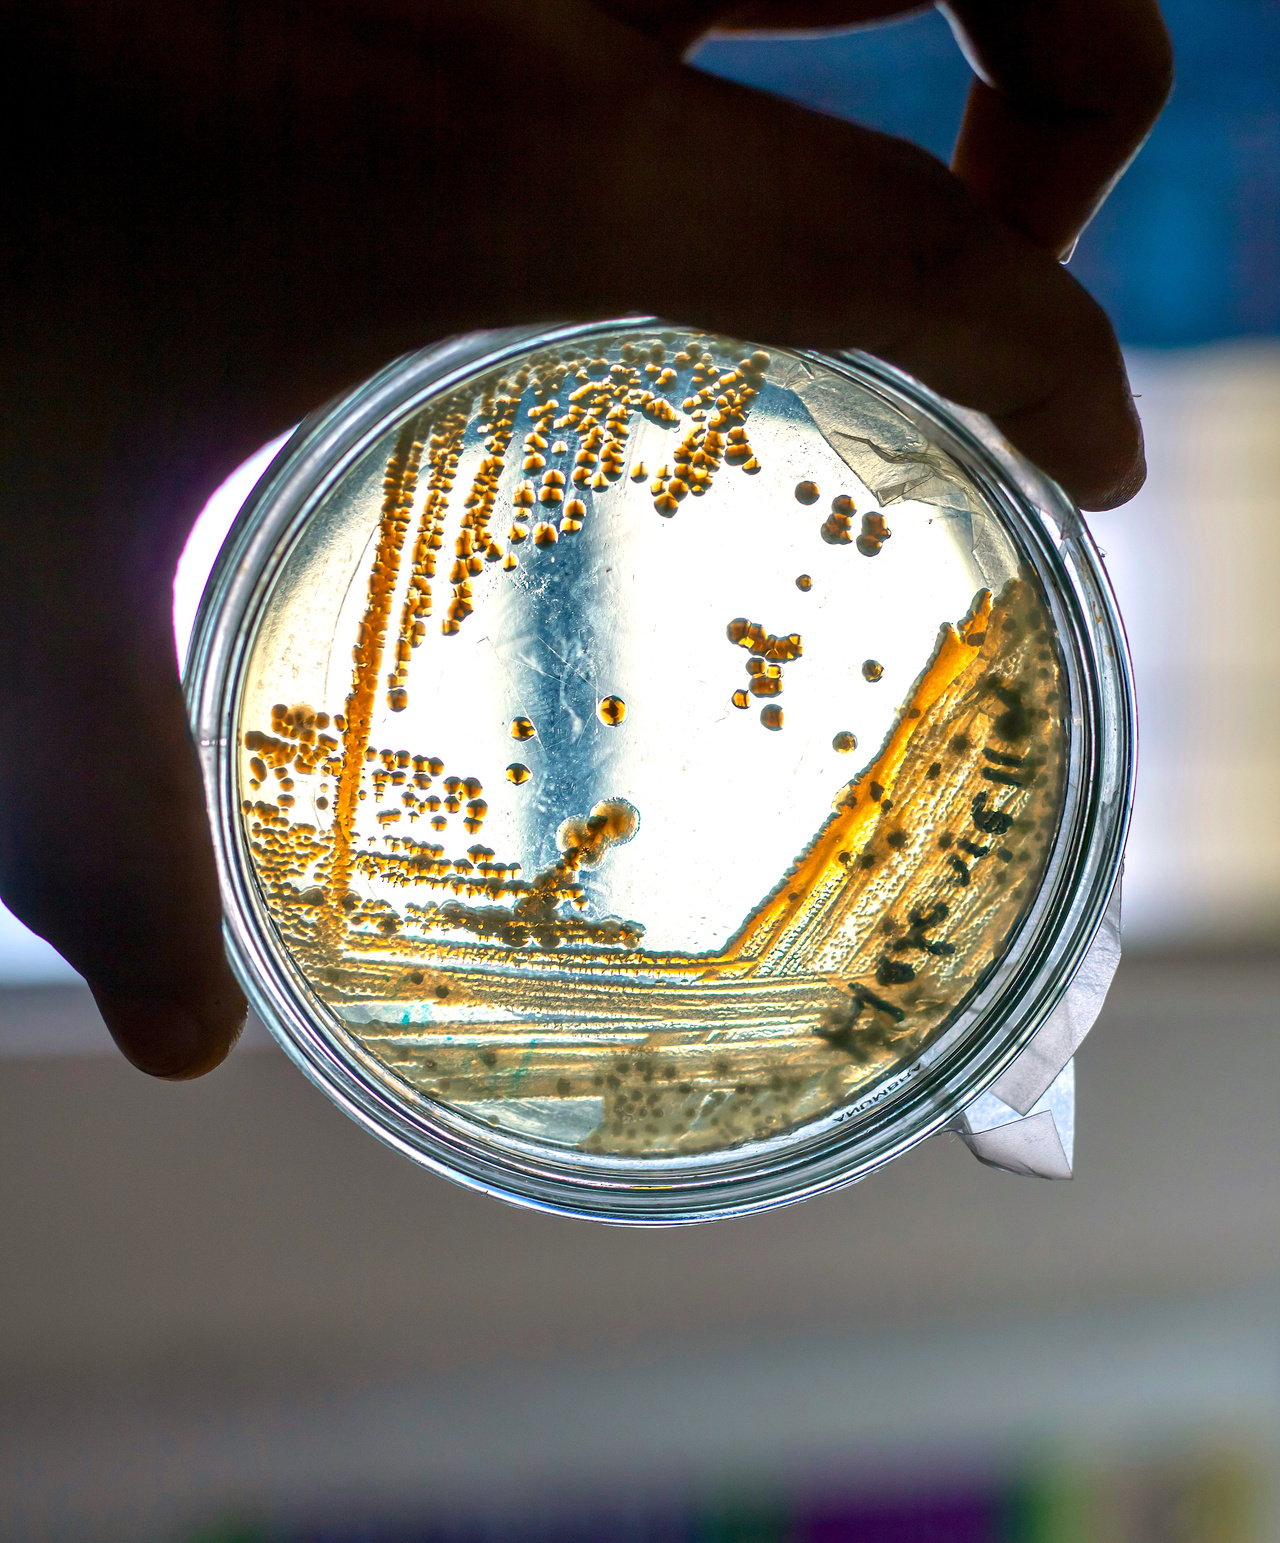
Listeria – the invisible guest on your dinner table

Quick version
Listeria is an uncommon but potentially life-threatening bacterial infection. It is spread through foods that we often perceive as completely everyday – cheese, salmon, cold cuts or ready meals. For most people, it only causes mild symptoms, but for vulnerable groups, the infection can have very serious consequences. By understanding how listeria works, and through simple but consistent food hygiene routines, the risk can be minimized. It is not about avoiding all foods that may contain the bacteria, but about making conscious choices – especially if you belong to a risk group.
What is listeria?
Listeria monocytogenes is a bacterium that can cause serious infections. Although listeria is one of the more uncommon foodborne illnesses in Sweden – between 50 and 100 reported cases per year – the disease can be life-threatening for certain groups. Pregnant women, the elderly and people with a weakened immune system are particularly vulnerable.
What makes listeria special is not only that it is dangerous, but that it can ingest everyday foods that we often perceive as completely harmless. A refrigerator that feels safe and clean can actually give the bacteria the opportunity to grow, which distinguishes it from many other food-poisoning bacteria.
How do people get listeria?
Listeria is found naturally in soil, water and among animals, often without causing illness in the animals themselves. For humans, infection usually occurs through food that is contaminated.
Examples of risky products:
- unpasteurized dairy products, especially soft blue cheeses and dessert cheeses
- raw or cold-smoked fish products, such as cured or smoked salmon
- sliced cold cuts that have been stored for a long time
- patés, ready-made salads and other chilled ready-made products
An important characteristic of listeria is that it can multiply at refrigerator temperature, which means that even properly stored foods can become dangerous if they stand for too long. This distinguishes it from many other bacteria that, on the contrary, are inhibited by cold. In everyday life, this can mean that a cheese tray that has been left for a few extra days, a lunch box that is not heated or a sliced cold cut in the refrigerator door can become a potential risk for sensitive people.
Symptoms of listeriosis
Listeriosis can vary depending on who is affected. In healthy adults, the symptoms are often relatively mild, such as fever, muscle aches, headaches or short-term stomach upset, and many people barely notice that they have had the infection.
In people at risk, however, the disease can be serious:
- fever and muscle aches that do not go away
- severe headache, nausea or diarrhea
- in severe cases, meningitis or blood poisoning (sepsis) develops
Pregnant women are at particular risk. Although the symptoms in the mother are often mild, the bacteria can pass to the fetus, which can lead to miscarriage, premature birth or serious damage to the baby. According to the CDC, approximately 20 percent of serious cases result in death, making listeria one of the most feared foodborne infections.
How is listeria detected?
If listeriosis is suspected, a medical examination is required. The most common method is a blood culture, which looks for the bacteria directly in the blood. If there are signs of meningitis, spinal fluid can also be analyzed.
The samples must be cultured in a laboratory in order for Listeria monocytogenes to be identified. It is therefore not an infection that can be detected through a simple rapid test or a regular blood test.
The Public Health Agency emphasizes in its guidelines that blood culture is the most common and reliable method for diagnosing invasive listeriosis.
How is listeria spread through food?
The listeria bacteria are spread primarily through food that has not been heated properly. Since it can survive and even grow at refrigerator temperatures, food stored in the refrigerator for a long time is particularly risky.
Examples of everyday transmission routes
- leftovers that have not been properly heated before eating
- cheeses made from unpasteurized milk
- ready-made meals and salads close to their best-before date
- smoked fish products that are consumed without heating
- sliced meats that have been opened for a long time in the refrigerator
The common denominator is refrigerated foods that are eaten without heating and that have a long shelf life.
Practical tips for reducing the risk of listeria
Although listeria is difficult to detect, the risk can be significantly reduced with good habits:
- Heat the food properly – the bacteria dies at 70°C.
- Eat fresh produce and avoid refrigerated food that has been sitting for too long.
- Keep the refrigerator cold, preferably below +4°C.
- Wash hands, knives and cutting boards thoroughly after contact with raw foods.
- Risk groups should avoid raw fish, unpasteurized cheese and other high-risk foods.
- Change dishcloths frequently and keep kitchen surfaces clean to avoid spread.